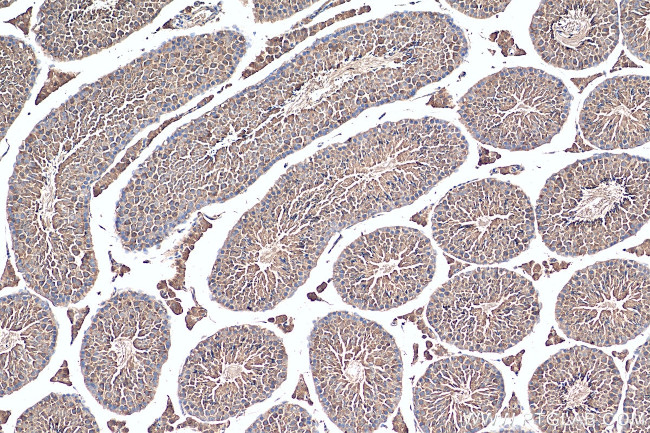
USH1G Antibody in Immunohistochemistry (Paraffin) (IHC (P))

Search
Proteintech
USH1G Polyclonal Antibody
{{$productOrderCtrl.translations['antibody.pdp.commerceCard.promotion.promotions']}}
{{$productOrderCtrl.translations['antibody.pdp.commerceCard.promotion.viewpromo']}}
{{$productOrderCtrl.translations['antibody.pdp.commerceCard.promotion.promocode']}}: {{promo.promoCode}} {{promo.promoTitle}} {{promo.promoDescription}}. {{$productOrderCtrl.translations['antibody.pdp.commerceCard.promotion.learnmore']}}
产品信息
21936-1-AP
种属反应
宿主/亚型
分类
类型
抗原
偶联物
形式
浓度
规格
纯化类型
保存液
内含物
保存条件
运输条件
产品详细信息
Immunogen sequence: LSFLVSFGA NIWCLDNDYH TPLDMAAMKG HMECVRYLDS IAAKQSSLNP KLVGKLKDKA FREAERRIRE CAKLQRRHHE RMERRYRREL AERSDTLSFS SLTSSTLSRR LQHLALGSHL PYSQATLHGT ARGKTKMQKK LERRKQGGEG TFKVSEDGRK SARSLSGLQL GSDVMFVRQG TYANPKEWGR APLRDMFLSD EDSVSRATLA AEPAHSEVST DSGHDSLFTR PGLGTMVFRR NYLSSGLHGL GREDGGLDGV GAPRGRLQSS PSLDDDSLGS ANSLQDRSCG EELPWDELDL GLDEDLEPET SPLETFLASL HMEDFAALLR QE (81-411 aa encoded by BC101099)
靶标信息
This gene encodes a protein that contains three ankyrin domains, a class I PDZ-binding motif and a sterile alpha motif. The encoded protein interacts with harmonin, which is associated with Usher syndrome type 1C. This protein plays a role in the development and maintenance of the auditory and visual systems and functions in the cohesion of hair bundles formed by inner ear sensory cells. Mutations in this gene are associated with Usher syndrome type 1G (USH1G).
仅用于科研。不用于诊断过程。未经明确授权不得转售。
篇参考文献 (0)
生物信息学
蛋白别名: Jackson shaker protein; pre-mRNA splicing regulator USH1G; Scaffold protein containing ankyrin repeats and SAM domain; scaffold protein, amkyrin repeats and SAM domain containing; scaffold protein, ankyrin repeats and SAM domain containing; Usher syndrome 1G homolog; Usher syndrome type-1G protein homolog
基因别名: js; Sans; Ush1g
UniProt ID: (Mouse) Q80T11
Entrez Gene ID: (Mouse) 16470